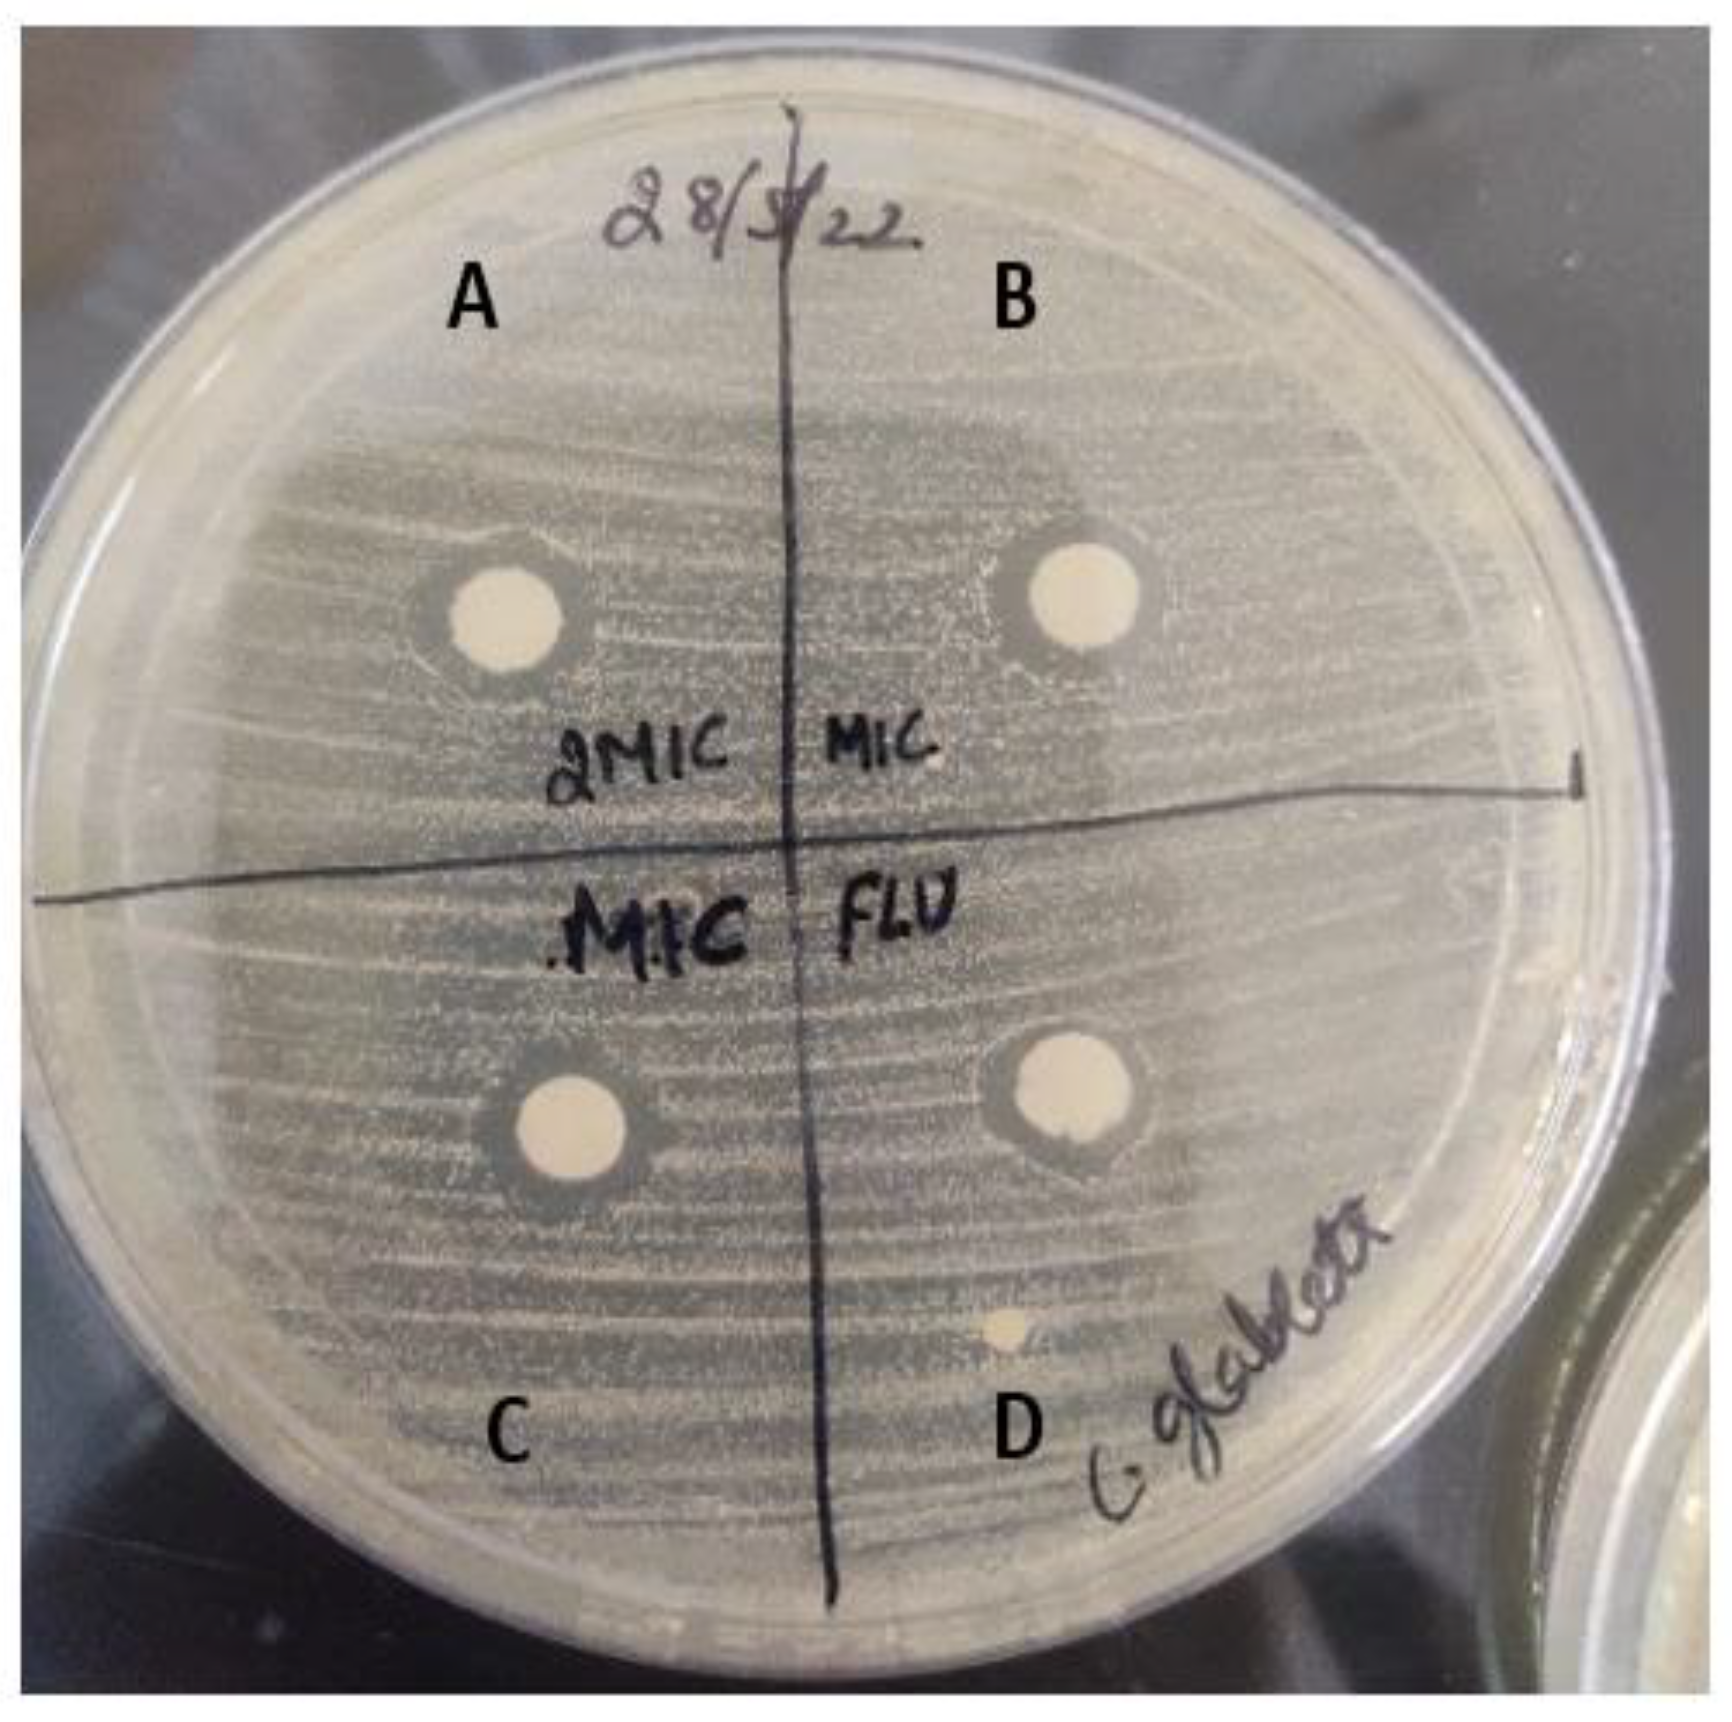
Molecules 28 04658 g007 Molecules 28 04658 g007
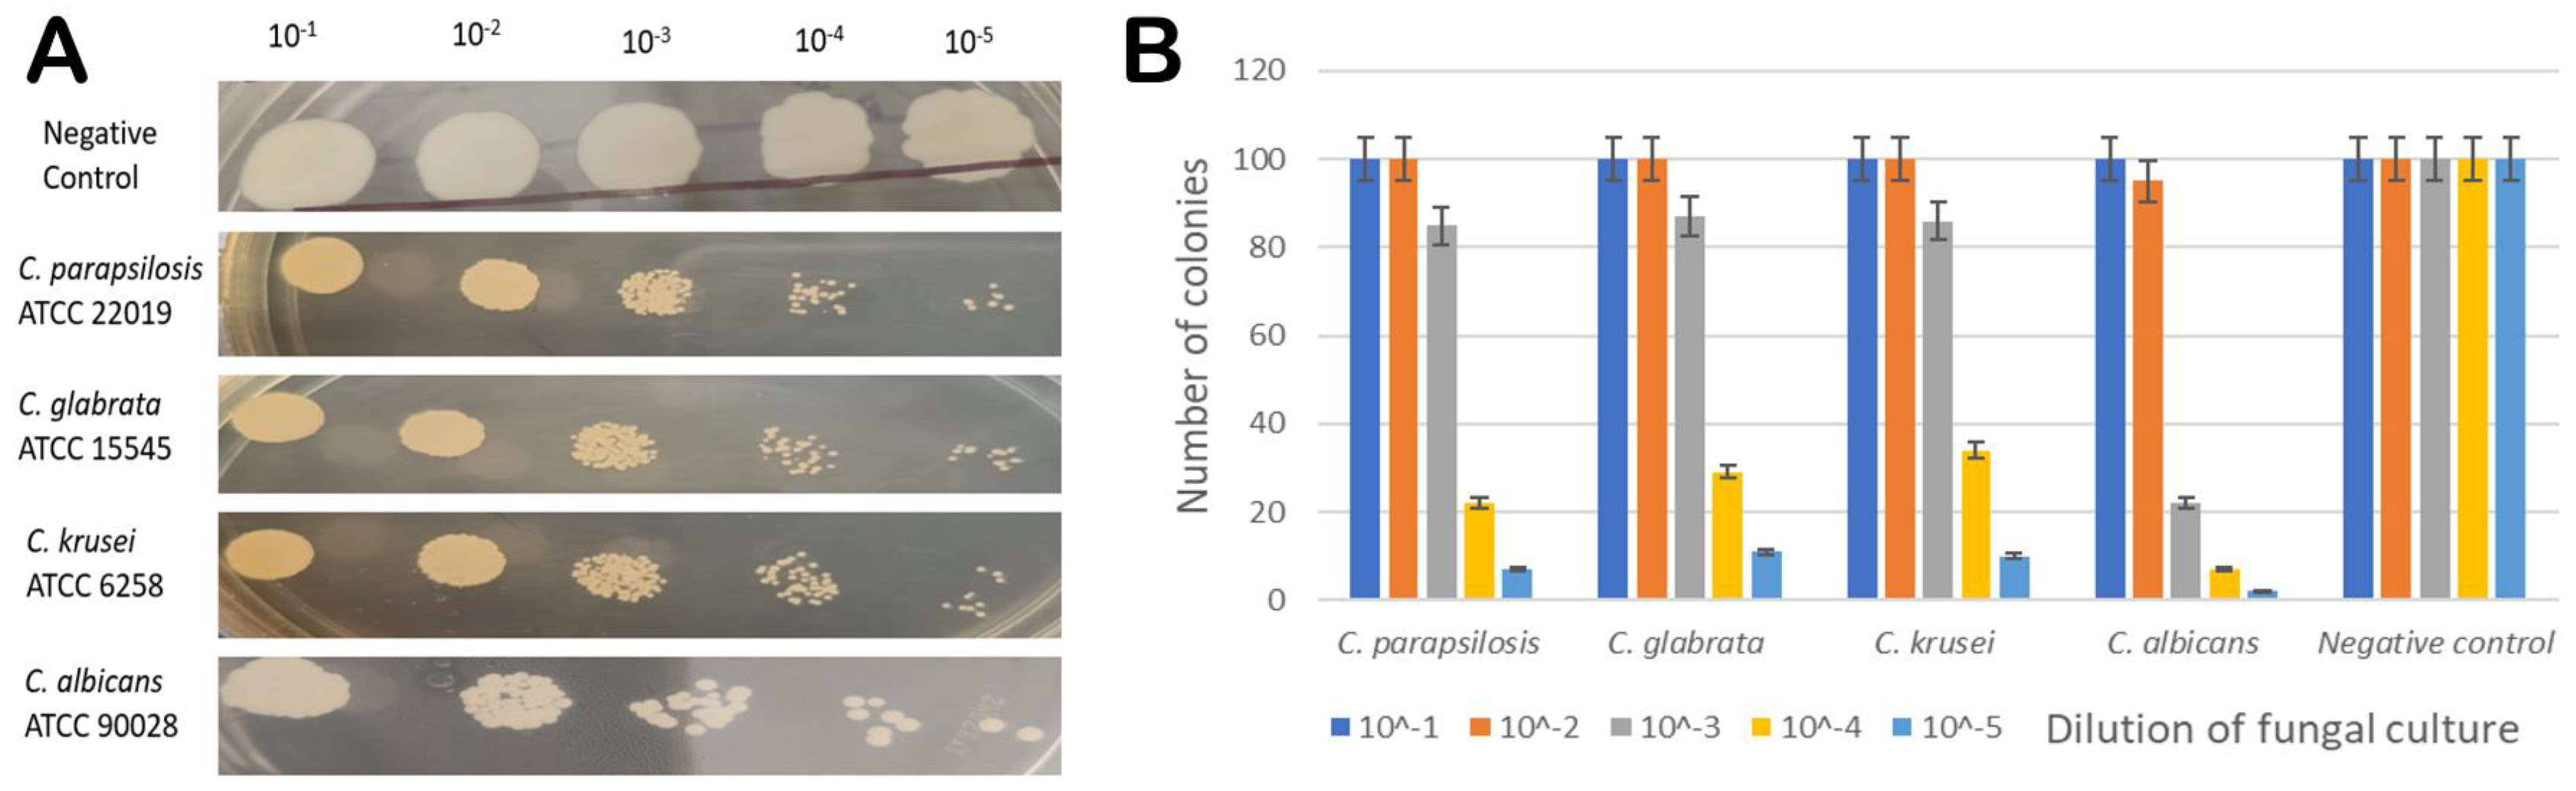
Molecules 28 04658 g008 Molecules 28 04658 g008

Identification of Sesamin from Sesamum indicum as a Potent Antifungal Agent Using an Integrated in Silico and Biological Screening Platform
Abstract
1. Introduction
2. Results and Discussion
2.1. Computational Details
2.2. Biological Evaluation
2.2.1. Drug Susceptibility Test Using Disc Diffusion Method
2.2.2. Minimum Inhibitory Concentration
2.2.3. Spot Assay
2.2.4. Synergistic Study
3. Materials and Methods
3.1. Computational Details
3.1.1. Phytochemical Library Preparation
3.1.2. Molecular Docking
3.1.3. Molecular Dynamics (MD)
3.1.4. ADMET/Pharmacokinetics Predictions and Bioactive Evaluation
3.2. Biological Evaluation of Sesamin as an Antifungal Agent
3.2.1. Growth Media and Strains Used
3.2.2. Inoculum Preparation
3.2.3. Disc Diffusion Assay
3.2.4. Spot Assay
3.2.5. Determination of the Minimum Inhibitory Concentration (MIC) and Minimum Fungicidal Concentration (MFC)
3.2.6. Synergistic Study/Checkerboard Microdilution Assay
4. Conclusions
Supplementary Materials
Author Contributions
Funding
Institutional Review Board Statement
Informed Consent Statement
Data Availability Statement
Acknowledgments
Conflicts of Interest
Sample Availability
References
- Talapko, J.; Juzbasic, M.; Matijevic, T.; Pustijanac, E.; Bekic, S.; Kotris, I.; Skrlec, I. Candida albicans—The Virulence Factors and Clinical Manifestations of Infection. J. Fungi. 2021, 7, 79. [Google Scholar] [CrossRef]
- Whaley, S.G.; Berkow, E.L.; Rybak, J.M.; Nishimoto, A.T.; Barker, K.S.; Rogers, P.D. Azole Antifungal Resistance in Candida albicans and Emerging Non-albicans Candida Species. Front. Microbiol. 2017, 7, 2173. [Google Scholar] [CrossRef] [PubMed]
- Prasad, R.; Kapoor, K. Multidrug resistance in yeast Candida. Int. Rev. Cytol. 2005, 242, 215–248. [Google Scholar] [CrossRef] [PubMed]
- Nakatani, Y.; Larsen, D.S.; Cutfield, S.M.; Cutfield, J.F. Major change in regiospecificity for the exo-1,3-beta-glucanase from Candida albicans following its conversion to a glycosynthase. Biochemistry 2014, 53, 3318–3326. [Google Scholar] [CrossRef]
- Mouyna, I.; Hartl, L.; Latge, J.P. β-1,3-glucan modifying enzymes in Aspergillus fumigatus. Front. Microbiol. 2013, 4, 81. [Google Scholar] [CrossRef]
- Latge, J.P. The cell wall: A carbohydrate armour for the fungal cell. Mol. Microbiol. 2007, 66, 279–290. [Google Scholar] [CrossRef]
- Brown, J.A.; Catley, B.J. Monitoring polysaccharide synthesis in Candida albicans. Carbohydr. Res. 1992, 227, 195–202. [Google Scholar] [CrossRef]
- Rast, D.M.; Baumgartner, D.; Mayer, C.; Hollenstein, G.O. Cell wall-associated enzymes in fungi. Phytochemistry 2003, 64, 339–366. [Google Scholar] [CrossRef] [PubMed]
- Adams, D.J. Fungal cell wall chitinases and glucanases. Microbiology 2004, 150, 2029–2035. [Google Scholar] [CrossRef]
- Larriba, G.; Andaluz, E.; Cueva, R.; Basco, R.D. Molecular biology of yeast exoglucanases. FEMS Microbiol. Lett. 1995, 125, 121–126. [Google Scholar] [CrossRef]
- San Segundo, P.; Correa, J.; Vazquez de Aldana, C.R.; del Rey, F. SSG1, a gene encoding a sporulation-specific 1,3-beta-glucanase in Saccharomyces cerevisiae. J. Bacteriol. 1993, 175, 3823–3837. [Google Scholar] [CrossRef] [PubMed]
- Stubbs, H.J.; Brasch, D.J.; Emerson, G.W.; Sullivan, P.A. Hydrolase and transferase activities of the beta-1,3-exoglucanase of Candida albicans. Eur. J. Biochem. 1999, 263, 889–895. [Google Scholar] [CrossRef]
- Xu, H.; Nobile, C.J.; Dongari-Bagtzoglou, A. Glucanase induces filamentation of the fungal pathogen Candida albicans. PLoS ONE 2013, 8, e63736. [Google Scholar] [CrossRef]
- Cutfield, S.M.; Davies, G.J.; Murshudov, G.; Anderson, B.F.; Moody, P.C.; Sullivan, P.A.; Cutfield, J.F. The structure of the exo-beta-(1,3)-glucanase from Candida albicans in native and bound forms: Relationship between a pocket and groove in family 5 glycosyl hydrolases. J. Mol. Biol. 1999, 294, 771–783. [Google Scholar] [CrossRef] [PubMed]
- Ogawa, T.; Nishio, J.; Okada, S. Effect of edible sesame oil on growth of clinical isolates of Candida albicans. Biol. Res. Nurs. 2014, 16, 335–343. [Google Scholar] [CrossRef]
- Nasim, N.; Sandeep, I.S.; Mohanty, S. Plant-derived natural products for drug discovery: Current approaches and prospects. Nucleus 2022, 65, 399–411. [Google Scholar] [CrossRef] [PubMed]
- Harikumar, K.B.; Sung, B.; Tharakan, S.T.; Pandey, M.K.; Joy, B.; Guha, S.; Krishnan, S.; Aggarwal, B.B. Sesamin manifests chemopreventive effects through the suppression of NF-kappa B-regulated cell survival, proliferation, invasion, and angiogenic gene products. Mol. Cancer Res. 2010, 8, 751–761. [Google Scholar] [CrossRef]
- Kumar, A.; Mishra, D.C.; Angadi, U.B.; Yadav, R.; Rai, A.; Kumar, D. Inhibition Potencies of Phytochemicals Derived from Sesame Against SARS-CoV-2 Main Protease: A Molecular Docking and Simulation Study. Front. Chem. 2021, 9, 744376. [Google Scholar] [CrossRef] [PubMed]
- Mahendra Kumar, C.; Singh, S.A. Bioactive lignans from sesame (Sesamum indicum L.): Evaluation of their antioxidant and antibacterial effects for food applications. J. Food Sci. Technol. 2015, 52, 2934–2941. [Google Scholar] [CrossRef] [PubMed]
- Andargie, M.; Vinas, M.; Rathgeb, A.; Moller, E.; Karlovsky, P. Lignans of Sesame (Sesamum indicum L.): A Comprehensive Review. Molecules 2021, 26, 883. [Google Scholar] [CrossRef]
- Michailidis, D.; Angelis, A.; Aligiannis, N.; Mitakou, S.; Skaltsounis, L. Recovery of Sesamin, Sesamolin, and Minor Lignans from Sesame Oil Using Solid Support-Free Liquid-Liquid Extraction and Chromatography Techniques and Evaluation of Their Enzymatic Inhibition Properties. Front. Pharmacol. 2019, 10, 723. [Google Scholar] [CrossRef]
- Ansari, M.A.; Fatima, Z.; Hameed, S. Sesamol: A natural phenolic compound with promising anticandidal potential. J. Pathog. 2014, 2014, 895193. [Google Scholar] [CrossRef]
- Alfuraydi, A.A.; Devanesan, S.; Al-Ansari, M.; AlSalhi, M.S.; Ranjitsingh, A.J. Eco-friendly green synthesis of silver nanoparticles from the sesame oil cake and its potential anticancer and antimicrobial activities. J. Photochem. Photobiol. B 2019, 192, 83–89. [Google Scholar] [CrossRef]
- Agbo, J.; Mpetga, J.D.S.; Bikanga, R.; Tchuenguem, R.T.; Tsafack, R.B.N.; Awouafack, M.D.; Dzoyem, J.P.; Ito, T.; Morita, H.; Tane, P. A New Benzophenanthridine Alkaloid from Caloncoba glauca. Nat. Prod. Commun. 2017, 12, 367–368. [Google Scholar] [PubMed]
- Chambers, R.S.; Broughton, M.J.; Cannon, R.D.; Carne, A.; Emerson, G.W.; Sullivan, P.A. An exo-beta-(1,3)-glucanase of Candida albicans: Purification of the enzyme and molecular cloning of the gene. J. Gen. Microbiol. 1993, 139, 325–334. [Google Scholar] [CrossRef]
- Pitson, S.M.; Seviour, R.J.; McDougall, B.M. Noncellulolytic fungal beta-glucanases: Their physiology and regulation. Enzym. Microb. Technol. 1993, 15, 178–192. [Google Scholar] [CrossRef]
- Chaffin, W.L.; Lopez-Ribot, J.L.; Casanova, M.; Gozalbo, D.; Martinez, J.P. Cell wall and secreted proteins of Candida albicans: Identification, function, and expression. Microbiol. Mol. Biol. Rev. 1998, 62, 130–180. [Google Scholar] [CrossRef] [PubMed]
- Chambers, R.S.; Walden, A.R.; Brooke, G.S.; Cutfield, J.F.; Sullivan, P.A. Identification of a putative active site residue in the exo-beta-(1,3)-glucanase of Candida albicans. FEBS Lett. 1993, 327, 366–369. [Google Scholar] [CrossRef]
- Patrick, W.M.; Nakatani, Y.; Cutfield, S.M.; Sharpe, M.L.; Ramsay, R.J.; Cutfield, J.F. Carbohydrate binding sites in Candida albicans exo-beta-1,3-glucanase and the role of the Phe-Phe ‘clamp’ at the active site entrance. FEBS J. 2010, 277, 4549–4561. [Google Scholar] [CrossRef]
- Morris, G.M.; Huey, R.; Lindstrom, W.; Sanner, M.F.; Belew, R.K.; Goodsell, D.S.; Olson, A.J. AutoDock4 and AutoDockTools4: Automated docking with selective receptor flexibility. J. Comput. Chem. 2009, 30, 2785–2791. [Google Scholar] [CrossRef] [PubMed]
- Zheng, X.; Polli, J. Identification of inhibitor concentrations to efficiently screen and measure inhibition Ki values against solute carrier transporters. Eur. J. Pharm. Sci. 2010, 41, 43–52. [Google Scholar] [CrossRef]
- Hatipoglu, N.; Hatipoglu, H. Combination antifungal therapy for invasive fungal infections in children and adults. Expert Rev. Anti. Infect Ther. 2013, 11, 523–535. [Google Scholar] [CrossRef] [PubMed]
- Lipinski, C.A.; Lombardo, F.; Dominy, B.W.; Feeney, P.J. Experimental and computational approaches to estimate solubility and permeability in drug discovery and development settings. Adv. Drug Deliv. Rev. 2001, 46, 3–26. [Google Scholar] [CrossRef] [PubMed]
- Berman, H.M.; Westbrook, J.; Feng, Z.; Gilliland, G.; Bhat, T.N.; Weissig, H.; Shindyalov, I.N.; Bourne, P.E. The Protein Data Bank. Nucleic Acids Res. 2000, 28, 235–242. [Google Scholar] [CrossRef]
- Tian, W.; Chen, C.; Lei, X.; Zhao, J.; Liang, J. CASTp 3.0: Computed atlas of surface topography of proteins. Nucleic Acids Res. 2018, 46, W363–W367. [Google Scholar] [CrossRef]
- Kapoor, N.; Ghorai, S.M.; Khuswaha, P.K.; Bandichhor, R.; Brogi, S. Butein as a potential binder of human ACE2 receptor for interfering with SARS-CoV-2 entry: A computer-aided analysis. J. Mol. Model 2022, 28, 270. [Google Scholar] [CrossRef] [PubMed]
- Sirous, H.; Chemi, G.; Campiani, G.; Brogi, S. An integrated in silico screening strategy for identifying promising disruptors of p53-MDM2 interaction. Comput. Biol. Chem. 2019, 83, 107105. [Google Scholar] [CrossRef]
- Daina, A.; Michielin, O.; Zoete, V. SwissADME: A free web tool to evaluate pharmacokinetics, drug-likeness and medicinal chemistry friendliness of small molecules. Sci. Rep. 2017, 7, 42717. [Google Scholar] [CrossRef] [PubMed]
- Hudzicki, J. Kirby-Bauer Disk Diffusion Susceptibility Test Protocol; American Society for Microbiology: Washington, DC, USA, 2009; Available online: https://www.asm.org/Protocols/Kirby-Bauer-Disk-Diffusion-Susceptibility-Test-Pro (accessed on 15 January 2023).
- Prasad, T.; Chandra, A.; Mukhopadhyay, C.K.; Prasad, R. Unexpected link between iron and drug resistance of Candida spp.: Iron depletion enhances membrane fluidity and drug diffusion, leading to drug-susceptible cells. Antimicrob. Agents Chemother. 2006, 50, 3597–3606. [Google Scholar] [CrossRef]
- CLSI (Clinical and Laboratory Standards Institute). Reference Method for Broth Dilution Antifungal Susceptibility Testing of Yeasts; Fourth Informational Supplement M27-S4.Wayne; Clinical and Laboratory Standard Institute: Wayne, PA, USA, 2012. [Google Scholar]
- Marques, M.B.; Brookings, E.S.; Moser, S.A.; Sonke, P.B.; Waites, K.B. Comparative in vitro antimicrobial susceptibilities of nosocomial isolates of Acinetobacter baumannii and synergistic activities of nine antimicrobial combinations. Antimicrob. Agents Chemother. 1997, 41, 881–885. [Google Scholar] [CrossRef] [PubMed]

| Name of Compound | Chemical Structure | Binding Energy (kcal/mol) | Inhibition Constant (nM) | Interacting Residues Involved in H Bonds |
|---|---|---|---|---|
| Sesamin (Lignan) |  | −12.21 | 1.11 | His254, Asn146, Gly306 |
| Pinoresinol (Lignan) |  | −11.50 | 3.71 | Asp145, Asn146, His254 |
| Caflanone (Flavonoid) |  | −11.48 | 3.80 | Asp145, Tyr255 |
| Herbacetin (Flavonoid) |  | −11.03 | 8.21 | Glu27, Glu192, Ser292, Leu304 |
| Compound | Pocket Grid Dimension for Molecular Docking Studies | Docking Score (kcal/mol) | Inhibition Constant (nM) | Residue Involved in Various Interactions |
|---|---|---|---|---|
| Sesamin | Grid-box center coordinates Center-x = 4.075 Center-y = 64.791 Center-z = 9.706 Grid-box Size size-x = 48 size-y = 62 size z = 46 | −12.21 | 1.11 | Phe144, Asp145, Asn146, Glu192, Phe229, Tyr255, Phe258, Gly306 |
| Entry | ΔGvdw a (kcal/mol) | ΔGcoul b (kcal/mol) | ΔGHbond c (kcal/mol) | ΔGLipo d (kcal/mol) | ΔGPack e (kcal/mol) | ΔGSolGB f (kcal/mol) | ΔGbind g (kcal/mol) |
|---|---|---|---|---|---|---|---|
| Sesamin | −45.74 | −14.29 | −1.14 | −29.53 | −4.91 | 26.31 | −61.67 |
| Pinoresinol | −43.91 | −12.11 | −1.07 | −26.82 | −2.11 | 24.67 | −59.31 |
| Caflanone | −35.17 | −9.23 | −1.04 | −27.14 | −0.73 | 19.16 | −53.22 |
| Herbacetin | −34.28 | −13.48 | −3.22 | −28.79 | −4.31 | 20.37 | −58.87 |
| Molecular Descriptor | Pinoresinol (Lignan) | Caflanone (Flavonoid) | Herbacetin (Flavonoid) | Sesamin (Lignan) | Fluconazole (Commercial Drug) | |
|---|---|---|---|---|---|---|
| Physicochemical parameter | ||||||
| Molecular formula | C20H22O6 | C21H20O6 | C15H10O7 | C20H18O6 | C13H12F2N6O | |
| Number of rotatable bonds | 4 | 4 | 1 | 5 | ||
| Molar refractivity | 94.90 | 104.20 | 78.03 | 90.00 | 70.71 | |
| Fraction Csp3 | 0.40 | 0.19 | 0.00 | 0.40 | 0.23 | |
| Number of heavy atoms | 26 | 27 | 22 | 26 | 22 | |
| Number of aromatic heavy atoms | 12 | 16 | 16 | 12 | 16 | |
| TPSA | 77.38 Å2 | 100.13 Å2 | 131.36 Å2 | 55.38 Å2 | 81.65 Å2 | |
| Lipophilicity | ||||||
| Log P o/w (iLOGP) | 2.67 | 3.29 | 1.50 | 3.46 | 0.41 | |
| Log P o/w (XLOGP3) | 2.28 | 5.03 | 2.17 | 2.68 | 0.35 | |
| Log P o/w (WLOGP) | 2.54 | 4.09 | 1.99 | 2.57 | 1.47 | |
| Log P o/w (MLOGP) | 1.17 | 1.31 | −0.56 | 1.98 | 1.47 | |
| Log P o/w (SILICOS-IT) | 2.66 | 4.28 | 1.54 | 3.25 | 0.71 | |
| Consensus Log P o/w | 2.26 | 3.60 | 1.33 | 2.79 | 0.88 | |
| Pharmacokinetics | ||||||
| GI-absorption | High | High | High | High | High | |
| BBB permeant | Yes | No | No | Yes | No | |
| P-gp substrate | Yes | No | No | No | Yes | |
| CYP1A2 inhibitor | No | No | Yes | No | No | |
| CYP2C19 inhibitor | No | No | No | Yes | Yes | |
| CYP2C9 inhibitor | No | Yes | No | No | No | |
| CYP2D6 inhibitor | Yes | No | Yes | Yes | No | |
| CYP3A4 inhibitor | Yes | No | Yes | Yes | No | |
| Log Kp (skin permeation) | −6.87 cm/s | −4.98 cm/s | −6.60 cm/s | −6.56 cm/s | −7.92 cm/s | |
| Druglikeness | ||||||
| Lipinski | Yes; 0 violation | Yes; 0 violation | Yes; 0 violation | Yes; 0 violation | Yes: 0 violation | |
| Ghose | Yes | Yes | Yes | Yes | Yes | |
| Veber | Yes | Yes | Yes | Yes | Yes | |
| Egan | Yes | Yes | Yes | Yes | Yes | |
| Muegge | Yes | No; 1 violation: XLOGP3>5 | Yes | Yes | Yes | |
| Bioavailability score | 0.55 | 0.55 | 0.55 | 0.55 | 0.55 |
| Name of Strains | Sesamin | Fluconazole | Amphotericin B | |||
|---|---|---|---|---|---|---|
| MIC | MFC | MIC | MFC | MIC | MFC | |
| C. albicans (ATCC 90028) | 16 | 32 | 2 | 4 | 1 | 2 |
| C. glabrata (ATCC 15545) | 16 | 32 | 1 | 2 | 0.5 | 2 |
| C. krusei (ATCC 6258) | 16 | 32 | 16 | 32 | 1 | 2 |
| C. parapsilosis (ATCC 22019) | 16 | 32 | 1 | 2 | 0.5 | 2 |
| Name of Strain | MIC (µg/mL) | |||||
|---|---|---|---|---|---|---|
| Alone Sesamin | Alone Fluconazole | Combination Sesamin+ Fluconazole | FICI | Interaction Mode | ||
| C. albicans (ATCC 90028) | 16 | 2 | 0.125 | 0.125 | 0.07 | Synergistic |
| C. parapsilosis (ATCC 22019) | 16 | 2 | 0.125 | 0.125 | 0.07 | Synergistic |
| C. krusei (ATCC 6258) | 16 | 16 | 0.5 | 0.125 | 0.03 | Synergistic |
| C. glabrata (ATCC 15545) | 16 | 1 | 0.125 | 0.125 | 0.13 | Synergistic |
Disclaimer/Publisher’s Note: The statements, opinions and data contained in all publications are solely those of the individual author(s) and contributor(s) and not of MDPI and/or the editor(s). MDPI and/or the editor(s) disclaim responsibility for any injury to people or property resulting from any ideas, methods, instructions or products referred to in the content. |
© 2023 by the authors. Licensee MDPI, Basel, Switzerland. This article is an open access article distributed under the terms and conditions of the Creative Commons Attribution (CC BY) license (https://creativecommons.org/licenses/by/4.0/).
Share and Cite
Wadhwa, K.; Kaur, H.; Kapoor, N.; Brogi, S. Identification of Sesamin from Sesamum indicum as a Potent Antifungal Agent Using an Integrated in Silico and Biological Screening Platform. Molecules 2023, 28, 4658. https://doi.org/10.3390/molecules28124658
Wadhwa K, Kaur H, Kapoor N, Brogi S. Identification of Sesamin from Sesamum indicum as a Potent Antifungal Agent Using an Integrated in Silico and Biological Screening Platform. Molecules. 2023; 28(12):4658. https://doi.org/10.3390/molecules28124658
Chicago/Turabian StyleWadhwa, Khushbu, Hardeep Kaur, Neha Kapoor, and Simone Brogi. 2023. "Identification of Sesamin from Sesamum indicum as a Potent Antifungal Agent Using an Integrated in Silico and Biological Screening Platform" Molecules 28, no. 12: 4658. https://doi.org/10.3390/molecules28124658
APA StyleWadhwa, K., Kaur, H., Kapoor, N., & Brogi, S. (2023). Identification of Sesamin from Sesamum indicum as a Potent Antifungal Agent Using an Integrated in Silico and Biological Screening Platform. Molecules, 28(12), 4658. https://doi.org/10.3390/molecules28124658







